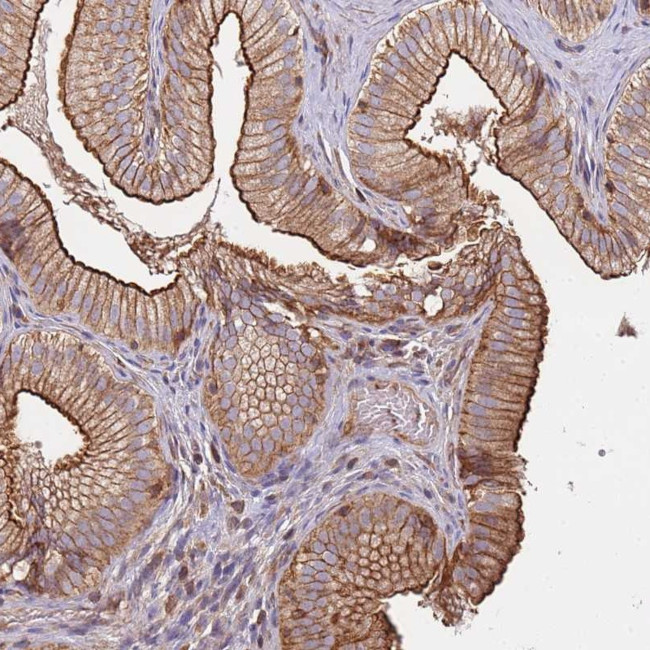
CYP2U1 Antibody in Immunohistochemistry (Paraffin) (IHC (P))

Search
Invitrogen
CYP2U1 Polyclonal Antibody
{{$productOrderCtrl.translations['antibody.pdp.commerceCard.promotion.promotions']}}
{{$productOrderCtrl.translations['antibody.pdp.commerceCard.promotion.viewpromo']}}
{{$productOrderCtrl.translations['antibody.pdp.commerceCard.promotion.promocode']}}: {{promo.promoCode}} {{promo.promoTitle}} {{promo.promoDescription}}. {{$productOrderCtrl.translations['antibody.pdp.commerceCard.promotion.learnmore']}}
产品信息
PA5-61307
种属反应
宿主/亚型
分类
类型
抗原
偶联物
形式
浓度
规格
纯化类型
保存液
内含物
保存条件
运输条件
RRID
产品详细信息
Immunogen sequence: QAEVFSDRPR VPLISIVTKE KGVVFAHYGP VWRQQRKFSH STLRHFGLGK LSLEPKIIEE FKYVKAEMQK HGEDPFCPFS IIS
Highest antigen sequence identity to the following orthologs: Mouse - 84%, Rat - 86%.
靶标信息
This gene encodes a member of the cytochrome P450 superfamily of enzymes. The cytochrome P450 proteins are monooxygenases which catalyze many reactions involved in drug metabolism and synthesis of cholesterol, steroids and other lipids. This enzyme is a hydroxylase that metabolizes arachidonic acid, docosahexaenoic acid, and other long chain fatty acids.
仅用于科研。不用于诊断过程。未经明确授权不得转售。
篇参考文献 (0)
生物信息学
蛋白别名: Cytochrome P450 2U1; cytochrome P450, family 2, subfamily U, polypeptide 1; Long-chain fatty acid omega-monooxygenase; spastic paraplegia 49; spastic paraplegia 56 (autosomal dominant); unnamed protein product
基因别名: CYP2U1; P450TEC; SPG49; SPG56
UniProt ID: (Human) Q7Z449
Entrez Gene ID: (Human) 113612